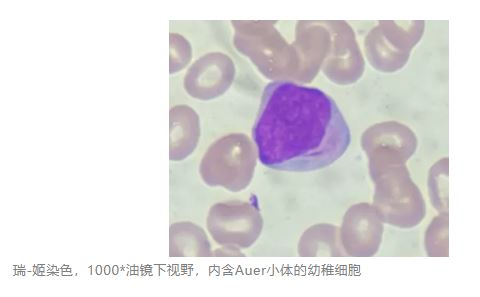
1775441088291239.jpg

散点图异常?差点发错血常规报告
作者:张紫惠,彭晶晶,龚常海,江秀旗等,广西壮族自治区来宾市兴宾区人民医院
当我从青葱校园踏上临床检验的实习之路,满怀期许又想大展宏图。我的实习第一站在临检组,让我切实感受到了现代科技的发展——流水线已成为实验室的标配,只要设定好拦截规则,自动审核便不成问题。但我的老师们时刻督导我,切不可被血常规 上的数字蒙蔽,散点图、直方图都要给予重视,推片镜检更是复核的金标准。
上的数字蒙蔽,散点图、直方图都要给予重视,推片镜检更是复核的金标准。
过硬的专业技能,才是我未来学习之路的核心方向。下面,我将以实习期遇到的一例隐匿性白血病展开分析。
案例经过
患者男,67岁,以糜烂性胃炎 就诊于消化/血液科,医生开具血常规及生化检查,在检测血常规时,主要指标(红细胞、血小板、白细胞总数)未见显著异常。这没有触犯血常规复检规则呀?而我的老师们让我推片镜检,找线索。
就诊于消化/血液科,医生开具血常规及生化检查,在检测血常规时,主要指标(红细胞、血小板、白细胞总数)未见显著异常。这没有触犯血常规复检规则呀?而我的老师们让我推片镜检,找线索。

初出茅庐的我只看数值,却忽略了那张色彩斑斓、藏着“潜台词”的白细胞散点图。带教老师义正辞严地说,它可不是报告的附属品,而是许多审核环节中不可或缺的破案关键。但偏偏有不少新手/老手,对它视而不见,一不留神,就踏进了漏报的雷区。说的可不就是我。
在等待染色的过程中,老师给我讲解了该患者的散点图。可见异常表现:散点图淋巴细胞区域中段与单核细胞交融镶嵌,淋巴细胞群出现散尾,这一情况触发了复检规则[1]。按照本组标准操作程序的要求,需进行外周血推片、染色、镜检复核。于是,我真的在镜下找到了细胞内细长的Auer小体[2]。
该类原始幼稚细胞:胞体大小较一致,呈圆形或类圆形,细胞质量少至中等,呈深蓝色或灰蓝色,可见少量嗜天青颗粒;细胞核大而圆,占细胞体积的2/3以上,核染色质呈细颗粒状,分布均匀,核仁明显(1-3个),呈淡蓝色或无色,核膜清晰。部分细胞可见胞质内细长的Auer小体,长约1-6μm,呈紫红色细杆状结构。
带教老师当即向首诊医生报告了这一情况,考虑为髓系非M3型白血病[3]可能性大。由于本院不具备实施化疗方案的条件,因此建议将患者转诊至上级医院接受进一步治疗。
讨论
关键形态学特征Auer小体的发现与判定
在本案例中,显微镜复核发现的“细长的棒状小体 ”是诊断急性髓系白血病
”是诊断急性髓系白血病 的决定性证据。Auer小体的存在具有极高的临床特异性,它是急性髓系白血病AML的重要形态学标志,而绝对不出现于急性淋巴细胞白血病
的决定性证据。Auer小体的存在具有极高的临床特异性,它是急性髓系白血病AML的重要形态学标志,而绝对不出现于急性淋巴细胞白血病 ALL中。这一特征使其成为鉴别诊断的定海神针。若在原始细胞中观察到Auer小体,可直接排除ALL,锁定诊断方向为AML、骨髓增生异常综合征
ALL中。这一特征使其成为鉴别诊断的定海神针。若在原始细胞中观察到Auer小体,可直接排除ALL,锁定诊断方向为AML、骨髓增生异常综合征 或慢性粒单核细胞白血病.
或慢性粒单核细胞白血病.
白细胞散点图的深度解析
散点图的物理原理:血细胞分析仪 利用流式细胞术,通过半导体激光照射细胞悬液,检测两个关键参数来识别白细胞亚群。侧向散射光SSC反映细胞内部结构的复杂程度,颗粒、染色质凝聚度,数值越高,表明细胞内颗粒或碎片越多;侧向荧光SFL:用核酸染料染色,反映细胞内的DNA/RNA含量。数值越高,表明细胞的核内含核酸物越丰富,如原始细胞、幼稚细胞。
利用流式细胞术,通过半导体激光照射细胞悬液,检测两个关键参数来识别白细胞亚群。侧向散射光SSC反映细胞内部结构的复杂程度,颗粒、染色质凝聚度,数值越高,表明细胞内颗粒或碎片越多;侧向荧光SFL:用核酸染料染色,反映细胞内的DNA/RNA含量。数值越高,表明细胞的核内含核酸物越丰富,如原始细胞、幼稚细胞。
本案例报告中,患者最显著的异常表现并非细胞计数,而是白细胞散点图的异常。在正常血常规散点图中,淋巴细胞位于左下方(体积小、颗粒少、核酸少),单核细胞位于中间区域,中性粒细胞位于右上方。

当出现“淋巴细胞与单核细胞区域融合”时,意味着存在一群细胞,其物理特性介于淋巴细胞和单核细胞之间:侧向散射光SSC颗粒高于淋巴细胞,但低于典型的中性粒细胞或早幼粒细胞。侧向荧光SFL:原始单核细胞或幼稚单核细胞虽然颗粒不如早幼粒细胞丰富,但其核仁明显、染色质疏松,核酸含量较高,导致其散点位置上移,与富含核酸的淋巴细胞区域发生重叠。最终与淋巴细胞区域撞车。

总结
在临床检验工作中,每一个细微的指标和图形都可能隐藏着重要的诊断线索。白血病的诊断并非仅表现于白细胞计数明显升高或原始细胞爆破。
这次因白细胞散点图异常差点漏诊白血病的经历,让我深刻认识到检验工作不仅需要扎实的专业知识,更需要严谨细致的工作态度。日常检验时,不能仅仅满足于常规项目的数值判断,对于散点图、直方图要给予足够重视。理论知识与实践操作紧密结合,时刻保持警惕,才能最大限度地避免误诊和漏诊,为临床诊断提供准确可靠的依据,真正发挥检验工作在疾病诊疗中的侦察兵作用。
【参考文献】
[1] CLSI.H26-A3.血液分析仪复检指南[M].3rd ed.Wayne:Clinical and Laboratory Standards Institute, 2015.
[2] 国际血液学标准化委员会(ICSH).外周血细胞形态学描述标准化建议[J]. International Journal of Laboratory Hematology,2015,37(2):152-161.
[3] 世界卫生组织(WHO).造血与淋巴组织肿瘤分类[M].修订第5版.里昂:国际癌症研究机构出版社,2022.
来源:检验医学网
